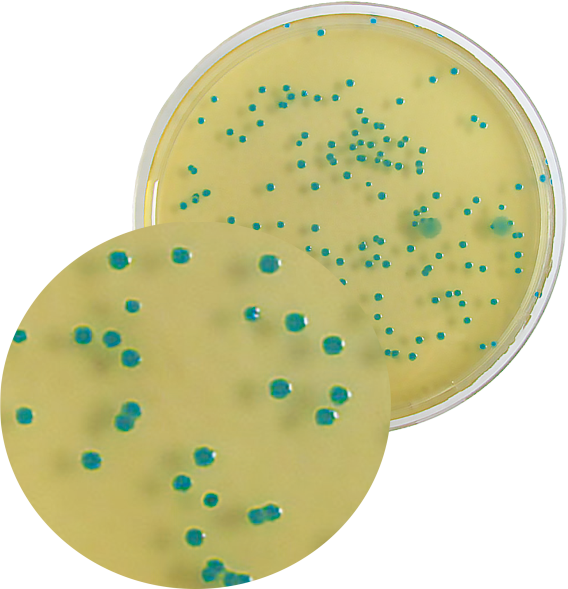

Gıda ve yem örneklerinde bütün Bacillus cereus grubuna ait muhtemel sporların ve vejetatif formların tespiti ve sınıflandırılması için kullanılan seçici katı besiyeridir.
Ürün Adı: COMPASS® Bacillus Cereus Agar
Ürün Kodu: BK189HA
Miktar: 500 g
Ürün Adı: COMPASS® Bacillus Cereus Selective Supplement
Ürün Kodu: BS08508
Miktar: 10 şişe x 500 mL
Ürün Adı: COMPASS® Bacillus Cereus Agar Selective Supplement
Ürün Kodu: BS06908
Miktar: 10 şişe x 100 mL
Ürün Adı: COMPASS® Bacillus Cereus Agar
Ürün Kodu: BM13008
Miktar: 10 şişe x 100 mL
Ürün Adı: COMPASS® Bacillus Cereus Agar
Ürün Kodu: BM12608
Miktar: 20 Petri plates Ø 90 mm